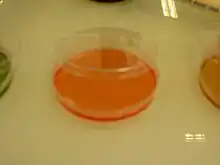

Agar manitol salado
Agar Manitol salado o siglas en inglés MSA (Mannitol salt agar) es un medio de cultivo que se utiliza normalmente en microbiología. Permite el crecimiento de bacterias Gram-positivas mientras inhibe el crecimiento de Gram-negativas. Este medio es importante en el laboratorio clínico debido a que es capaz de distinguir los microorganismo patogénicos en un corto periodo de tiempo. Contiene una alta concentración (~7.5%-10%) de sal (NaCl), haciéndolo selectivo para Staphylococcus (y Micrococcaceae) debido su alta concentración de NaCl es inhibitorio para la mayoría de las bacterias Gram negativas. Además contiene manitol otro inhibidor de bacterias Gram negativas y un indicador de pH indicador de fermentación ; rojo de fenol.
Coagulasa-positivo Staphylococcus producen colonias amarillas con zonas amarillas, mientras que coagulasa-negativo Staphylococcus producen colonias rojas o ligeramente rosadas sin cambio alguno al medio. Si un organismo es capaz de fermentar el manitol, un subproducto ácido es creado que hace que el rojo de fenol cambie a amarillo. Se usa para el aislamiento selectivo de colonias de Staphylococcus sospechosas de ser patógenas.
Posibles resultados

- Gram - : crecimiento inhibido[1]
Composición típica
El agar manitol salado suele tener la siguiente composición:[2]
- 5.0 g/L digerido enzimático de caseína
- 5.0 g/L digerido enzimático de tejido animal
- 1.0 g/L extracto de carne de vaca
- 10.0 g/L D-manitol
- 75.0 g/L NaCl
- 0.025 g/L rojo de fenol
- 15.0 g/L agar
- pH 7.4 ± 0.2 at 25 °C
Referencias
- Bachoon, Dave S., and Wendy A. Dustman. Microbiology Laboratory Manual. Ed. Michael Stranz. Mason, OH: Cengage Learning, 2008. Exercise 8, "Selective and Differential Media for Isolation" Print.
- United States Pharmacopeial Convention. 1995. The United States Pharmacopeia, 23rd ed. The United States Pharmacopeial Convention, Rockville, MD.
Bachoon, Dave S., and Wendy A. Dustman. Microbiology Laboratory Manual. Ed. Michael Stranz. Mason, OH: Cengage Learning, 2008. Exercise 8, "Selective and Differential Media for Isolation" Print.